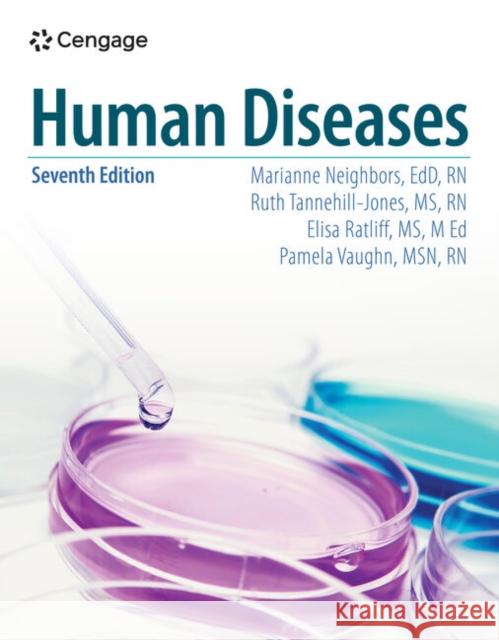
Human Diseases Pamela (Clark State College, Ohio) Vaughn 9798214116167

Wyniki wyszukiwania:
wyszukanych pozycji: 16
 |
...But They Call Me Sonny
ISBN: 9781426924385 / Angielski / Twarda / 2011 / 720 str. Termin realizacji zamówienia: ok. 16-18 dni roboczych. Pamela lost her dad when she was three. Later, she begins a search to find a grandfather presented by the loss of her father. Armed with a mission to find him, the facts start to skew. Clues twist and turn; and then entwine to such a degree she bumps into her dad's story. and learns the only way to find the man that fate has chosen to leave behind is that first she must go through her dad. Both on the same path, but forty years apart, and both in search of the same man, do the gods lead them to the one they want so desperately to find?
Fourteen and growing up in the streets, Sonny can t... Pamela lost her dad when she was three. Later, she begins a search to find a grandfather presented by the loss of her father. Armed with a mission to ...
|
cena:
226,37 |
 |
...But They Call Me Sonny
ISBN: 9781426924378 / Angielski / Miękka / 2011 / 720 str. Termin realizacji zamówienia: ok. 16-18 dni roboczych. Pamela lost her dad when she was three. Later, she begins a search to find a grandfather presented by the loss of her father. Armed with a mission to find him, the facts start to skew. Clues twist and turn; and then entwine to such a degree she bumps into her dad's story. and learns the only way to find the man that fate has chosen to leave behind is that first she must go through her dad. Both on the same path, but forty years apart, and both in search of the same man, do the gods lead them to the one they want so desperately to find?
Fourteen and growing up in the streets, Sonny can t... Pamela lost her dad when she was three. Later, she begins a search to find a grandfather presented by the loss of her father. Armed with a mission to ...
|
cena:
178,76 |
 |
Welcome To Briarwood
ISBN: 9798322559481 / Angielski / Miękka / 2024 / 178 str. Termin realizacji zamówienia: ok. 16-18 dni roboczych. |
cena:
104,97 |
 |
Remote Sensing Tools for Exploration: Observing and Interpreting the Electromagnetic Spectrum
ISBN: 9781489982575 / Angielski / Miękka / 2014 / 346 str. Termin realizacji zamówienia: ok. 16-18 dni roboczych. Remote Sensing from a New Perspective The idea for this book began many years ago, when I was asked to teach a course on remote sensing. Not long before that time, I had been part of the effort to develop the first database for planetary data with a common digital array format and interactive processing capabilities to correlate those data easily: the lunar consortium. All the available lunar remote sensing data were included, orbital and ground-based, ranging across the entire electromagnetic spectrum. I had used this powerful tool extensively, and, in that spirit, I was determined to create...
Remote Sensing from a New Perspective The idea for this book began many years ago, when I was asked to teach a course on remote sensing. Not long befo...
|
cena:
613,74 |
 |
Extreme Exploration: Celebrating And Applying Lessons Learned From The Apollo Expeditions
ISBN: 9783032017338 / Angielski Termin realizacji zamówienia: ok. 16-18 dni roboczych. |
cena:
114,53 |
 |
How to Boil Water
ISBN: 9781079158625 / Angielski / Miękka / 2019 / 180 str. Termin realizacji zamówienia: ok. 16-18 dni roboczych. |
cena:
37,59 |
 |
Constant-Scale Natural Boundary Mapping to Reveal Global and Cosmic Processes
ISBN: 9781461477617 / Angielski / Miękka / 2013 / 116 str. Termin realizacji zamówienia: ok. 16-18 dni roboczych. Whereas conventional maps can be expressed as outward-expanding formulae with well-defined central features and relatively poorly defined edges, Constant Scale Natural Boundary (CSNB) maps have well-defined boundaries that result from natural processes and thus allow spatial and dynamic relationships to be observed in a new way useful to understanding these processes. CSNB mapping presents a new approach to visualization that produces maps markedly different from those produced by conventional cartographic methods. In this approach, any body can be represented by a 3D coordinate system. For a...
Whereas conventional maps can be expressed as outward-expanding formulae with well-defined central features and relatively poorly defined edges, Const...
|
cena:
204,55 |
 |
Mercury's Interior, Surface, and Surrounding Environment: Latest Discoveries
ISBN: 9781493922437 / Angielski / Miękka / 2015 / 97 str. Termin realizacji zamówienia: ok. 16-18 dni roboczych. This SpringerBrief details the MESSENGER Mission, the findings of which present challenges to widely held conventional views and remaining mysteries surrounding the planet. The work answers the question of why Mercury is so dense, and the implications from geochemical data on its planetary formation. It summarizes imaging and compositional data from the terrestrial planet surface processes and explains the geologic history of Mercury. It also discusses the lack of southern hemisphere coverage. Our understanding of the planet Mercury has been in a transitional phase over the decades... This SpringerBrief details the MESSENGER Mission, the findings of which present challenges to widely held conventional views and remaining mysterie... |
cena:
204,55 |
 |
Remote Sensing Tools for Exploration: Observing and Interpreting the Electromagnetic Spectrum
ISBN: 9781441968296 / Angielski / Twarda / 2010 / 346 str. Termin realizacji zamówienia: ok. 16-18 dni roboczych. Remote Sensing from a New Perspective The idea for this book began many years ago, when I was asked to teach a course on remote sensing. Not long before that time, I had been part of the effort to develop the first database for planetary data with a common digital array format and interactive processing capabilities to correlate those data easily: the lunar consortium. All the available lunar remote sensing data were included, orbital and ground-based, ranging across the entire electromagnetic spectrum. I had used this powerful tool extensively, and, in that spirit, I was determined to create...
Remote Sensing from a New Perspective The idea for this book began many years ago, when I was asked to teach a course on remote sensing. Not long befo...
|
cena:
613,74 |
 |
Dynamic Planet: Mercury in the Context of Its Environment
ISBN: 9780387482101 / Angielski / Twarda / 2007 / 220 str. Termin realizacji zamówienia: ok. 16-18 dni roboczych. This book views Mercury as a whole in the context of its environment. It illustrates what we know and what we need to know, and why understanding Mercury is so crucial to our understanding of solar system origin and current processes on Earth. The book describes our current state of knowledge for Mercury and interactions between interior, exterior, and space environment which are highly dynamic and thus critical to understanding Mercury as a system. This book views Mercury as a whole in the context of its environment. It illustrates what we know and what we need to know, and why understanding M... |
cena:
613,74 |
 |
Topsy Turvy Christmas
ISBN: 9781974284412 / Angielski / Miękka / 2017 / 126 str. Termin realizacji zamówienia: ok. 16-18 dni roboczych. |
cena:
33,56 |
 |
Dynamic Planet: Mercury in the Context of Its Environment
ISBN: 9781441923707 / Angielski / Miękka / 2010 / 220 str. Termin realizacji zamówienia: ok. 16-18 dni roboczych. UNDERSTANDING THE PLANET MERCURY Thirty years have elapsed since the one and only mission to Mercury, Mariner 10, performed three ?ybys of the planet, capturing moderate-reso- tion (100 m at best) images of one hemisphere (45% of the surface) and d- covering that Mercury could be the only other terrestrial planet to have a global magnetic ?eld and core dynamo analogous to the Earth s. At the time of this writing, the MESSENGER mission to Mercury has been launched. We are still a couple of years away from the ?rst of the next ?ybys of Mercury, by MESSENGER, on its way to insertion into a...
UNDERSTANDING THE PLANET MERCURY Thirty years have elapsed since the one and only mission to Mercury, Mariner 10, performed three ?ybys of the planet,...
|
cena:
613,74 |
 |
Life Reflections: Create a Video Heirloom
ISBN: 9780989204705 / Angielski / Miękka / 2013 / 134 str. Termin realizacji zamówienia: ok. 16-18 dni roboczych. Life Reflections video preserves your family history in a new way--it reflects the essence of your aging parents or grandparents. This easy-to-understand book guides the amateur videographer in the creation of a treasured video heirloom using equipment you already own. Capture your grandpas's stories as well as the twinkle of his eyes and loud guffaw. Use a smartphone or camcorder to preserve for generations his wisdom and values, his life lessons.
Life Reflections video preserves your family history in a new way--it reflects the essence of your aging parents or grandparents. This easy-to-underst...
|
cena:
62,80 |
 |
The Book of Sainte Foy
ISBN: 9780812215120 / Angielski / Miękka / 1995 / 344 str. Termin realizacji zamówienia: ok. 30 dni roboczych. The miracle stories surrounding Sainte Foy form one of the most complete sets of material relating to a medieval saint's cult and its practices. Pamela Sheingorn's superb translation from the Medieval Latin texts now makes this literature available in English. The Book of Sainte Foy recounts the virgin saint's martyrdom in the third century (Passio), the theft of her relics in the late ninth century by the monks of the monastery at Conques (Translatio), and her diverse miracles (Liber miraculorum); also included is a rendering of the Proven&cceil;al Chanson de...
The miracle stories surrounding Sainte Foy form one of the most complete sets of material relating to a medieval saint's cult and its practices. Pamel...
|
cena:
142,26 |
|
Human Diseases
ISBN: 9798214116167 / Angielski / Miękka / 2026 / 624 str. Termin realizacji zamówienia: ok. 30 dni roboczych. |
cena:
495,42 |
 |
Nheg Edguide
ISBN: 9781790786046 / Angielski / Miękka / 2018 / 50 str. Termin realizacji zamówienia: ok. 16-18 dni roboczych. |
cena:
46,17 |










